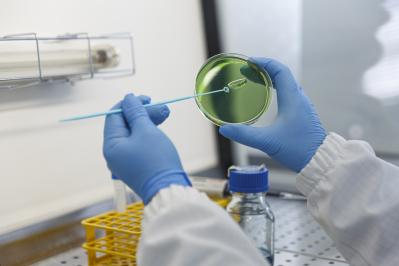
renolab header img home clean
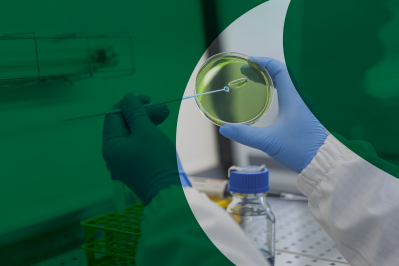
renolab header img home

GLP Studies
for Regulatory
Registration

Fields of
Application
Renolab is a laboratory certified by the Italian Ministry of Health for carrying out Studies according to Good Laboratory Practices (GLP).
The laboratory offers a wide range of analytical services for registration purposes, mainly in the field of agrochemicals and biocides, but also in the sectors of chemicals (REACH and CLP), biostimulants, biopesticides, cosmetics and medical devices according to ISO 17025.

Renolab –
a Tentamus company
The Renolab Test Centre has been certified according to GLP (Good Laboratory Practices) for over twenty years. Thanks to its highly qualified personnel and advanced instrumentation, Renolab provides a wide range of analytical services to support product registration, mainly in the fields of:
- Agrochemicals
- Biopesticides
- Biocides
- Cosmetics
- Medical Devices
- Fertilisers and Biostimulants
Since 2018, Renolab has been part of the Tentamus Group in Italy.
ABOUT TENTAMUS
Tentamus GmbH is a global network of specialised laboratories and companies, which has been working in the field of agrifood safety, cosmetics, pharmaceuticals and medical products since 2011. The Group currently boasts over 90 branches worldwide, all of which are a market leader in their sector, with over 4,000 highly qualified employees. Through our network of laboratories and companies, we are able to satisfy the increasing demands of our clients

NEWS
We would like to keep you informed!
In our news section, we provide you with current trends, industry updates and news from our Tentamus laboratories.





